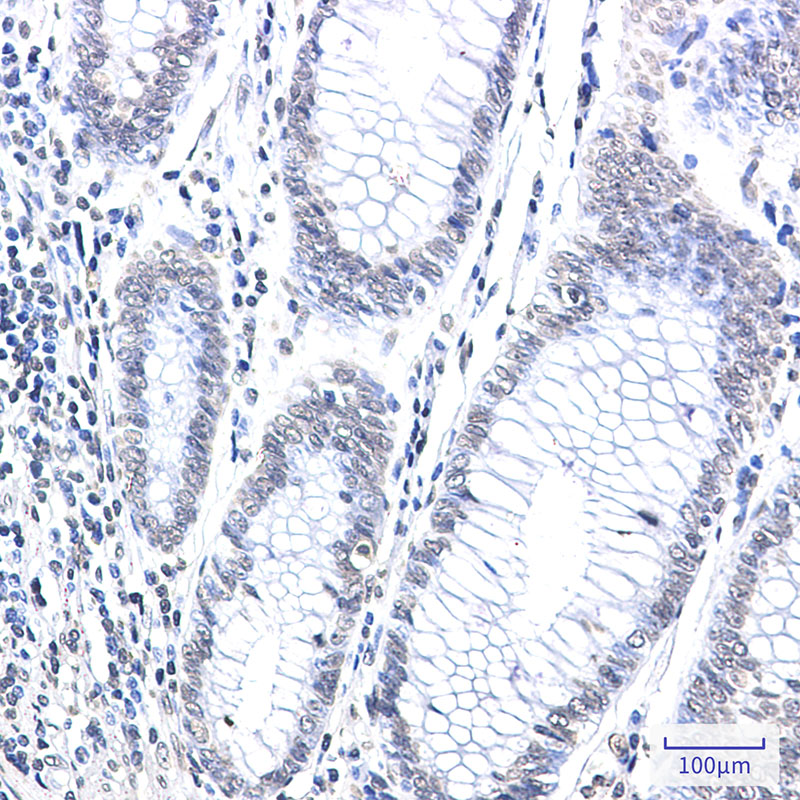

-
分类: 科研抗体货号: P22314别名: Crk L; Crk like protein; Crkl; Crkol应用: WB,IF反应种属: Human
-
分类: 科研抗体货号: P22295别名: MIC2; HBA71; MIC2X; MIC2Y; MSK5X应用: WB,IP,IHC,IF反应种属: Human
-
分类: 科研抗体货号: P22276别名: C13orf34应用: WB,IP反应种属: Human,Rat
-
分类: 科研抗体货号: P22313别名: REL应用: WB,IP反应种属: Human
-
分类: 科研抗体货号: P22294别名: DPP4; ADCP2; CD26; Dipeptidyl peptidase 4; ADABP; Adenosine deaminase complexing protein 2; ADCP-2; Dipeptidyl peptidase IV; DPP IV; T-cell activation antigen CD26; TP103; CD26应用: WB反应种属: Human
-
分类: 科研抗体货号: P22275别名: BMI1; PCGF4; RNF51; Polycomb complex protein BMI-1; Polycomb group RING finger protein 4; RING finger protein 51应用: WB,IP,IF反应种属: Human,Mouse,Rat
-
分类: 科研抗体货号: P22312别名: Cps1; CPSase 1; CPSase I; CPSASE1; MS738应用: WB,IP,IHC反应种属: Human
-
分类: 科研抗体货号: P22293别名: hly9; mLY9; CD229; SLAMF3应用: WB反应种属: Human
-
分类: 科研抗体货号: P22274别名: FP497; MGC15319; MGC42355; BID应用: WB,IP,IHC,IF反应种属: Human
-
分类: 科研抗体货号: P22311别名: CFL1; CFL; Cofilin-1; 18 kDa phosphoprotein; p18; Cofilin; non-muscle isoform应用: WB,IHC,IF反应种属: Human

鄂公网安备42018502007531号
鄂公网安备42018502007531号

